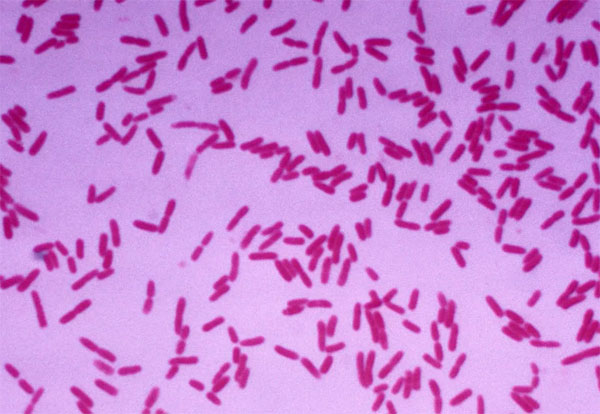
微生物在水產養殖環境修復中的作用

水產養殖中,水體的顏色是一個重要的指標,它可以反映出養殖對象的健康狀況以及水體的生態環境。因此,了解和識別不同的水色以及它們產生的原因,對于養殖業者……

一、農民思想解放的重要性 在推進農業現代化過程中,我們首先需要解決的是農民群眾的思想問題。在一些地方,許多農民仍然堅守著老一輩的思想傳統,他們依靠傳……

一、精準把握首次驅蟲時機,有效降低寄生蟲感染率 要想取得理想的驅蟲效果,選擇適當的驅蟲時機至關重要。根據2014年在華中地區進行的春季驅蟲時間調研結果,……

硝化細菌是指利用氨或亞硝酸鹽作為主要生存能源,以及利用二氧化碳作為主要碳源的一類細菌。硝化細菌分為硝化細菌和亞硝化細菌。亞硝化細菌的主要功能是將氨氮……

飼料對于水產行業的影響深遠且復雜,它如同一把雙刃劍,既為行業帶來了翻天覆地的變革和巨大的經濟利益,也引發了一系列新的生態問題。接下來,我們將從多個角……

pH值是評估養殖水體狀況的一個關鍵指標,它與水體中的多種化學平衡系統密切相關,特別是CO32–HCO3–CO2緩沖體系、Ca2+-CaCO3固體緩沖系統,同時還……
微生物在水產養殖環境及其生物循環中扮演著至關重要的角色。它們能夠直接或間接地作用于養殖生物和它們所處的環境,有效地分解有機物,如養殖生物的排泄物、未……

懸浮物,顧名思義,是指懸浮在水中的固體物質。包括不溶于水中的無機物和有機物,如泥沙、黏土、原生動物、藻類、細菌、病毒微生物等。主要會造成水體渾濁,使……

循環水養殖泡沫分離器(蛋白分離器)工作原理 循環水養殖泡沫分離器又稱為蛋白質分離器、蛋白質除沫器、“泡泡機”等。它是利用水中的氣泡表面可以吸附混雜在水……

在工廠化水產養殖中,如何控制水體的PH,對養殖成功與否起到了一定影響,那么水產養殖中,pH變化對養殖會產生什么樣的影響呢?下面我們就這個問題進行討論。 p……

集裝箱循環水養殖模式是在池塘工廠化循環水養殖技術模式的基礎上,依靠科技創新實現批量化制造、模塊化組裝,變革了水產養殖方式,實現了傳統池塘養殖到工廠化……

在進行工廠化水產養殖時,我們經常會聽到人說“養魚先養水”,足見所有人對養水的重視度了。但什么樣的水是好水可不是憑養殖戶和技術員的肉眼分辨出來的,即使再……

鱘魚作為一種珍貴的高檔水產品,其蛋白質含量較高,我國在漁業養殖生產中占有一定的地位。隨著漁業養殖規模的擴大和養殖鱘魚品種的增多,養殖中存在的一些問題……

眾所周知,養殖水體中產生的亞硝酸鹽,是氨轉化為硝酸鹽的中間產物。由于蝦塘殘餌、糞便的積累過多,使氨氮不斷產生;加之硝化細菌群的天生惰性和代謝條件的挑……

魚塘養魚水中的溶解氧一般來源于浮游植物的光合作用、大氣中擴散溶于水中的氧、人工機械增氧三種途徑。魚類耗氧與魚的種類、年齡、體重及活動水平有關,同時與……

循環水養殖投喂對魚類生長非常重要,會直接影響魚類的生長發育。 幼魚喂食要遵循少量多次原則,魚慢慢長大投喂逐漸固定時間和頻率,就可以上自動投餌機。 在……